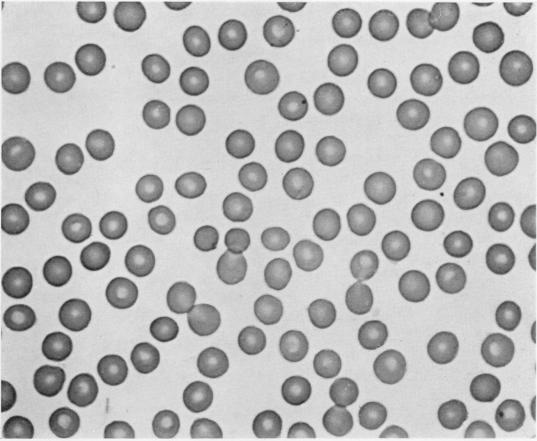
https://cdn.ncbi.nlm.nih.gov/pmc/blobs/c0d6/424884/9f28a6d6061e/jcinvest00544-0185-a.jpg
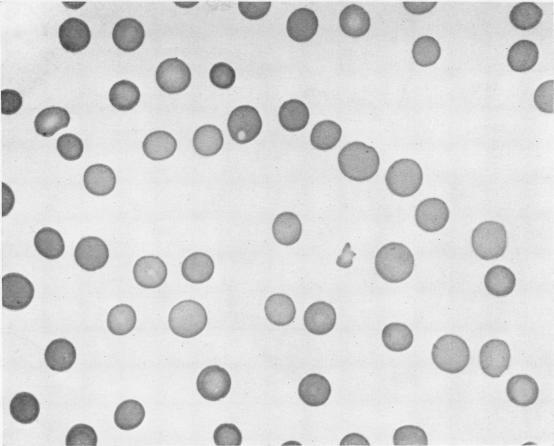
https://cdn.ncbi.nlm.nih.gov/pmc/blobs/c0d6/424884/080a5011e399/jcinvest00544-0183-a.jpg

MACROCYTIC ANEMIA IN PREGNANT WOMEN WITH VITAMIN B DEFICIENCY.
作者信息
Elsom K O, Sample A B
机构信息
Gastro-Intestinal Section of the Medical Clinic, Hospital of the University of Pennsylvania, Philadelphia.
出版信息
J Clin Invest. 1937 May;16(3):463-74. doi: 10.1172/JCI100871.
Abstract
摘要